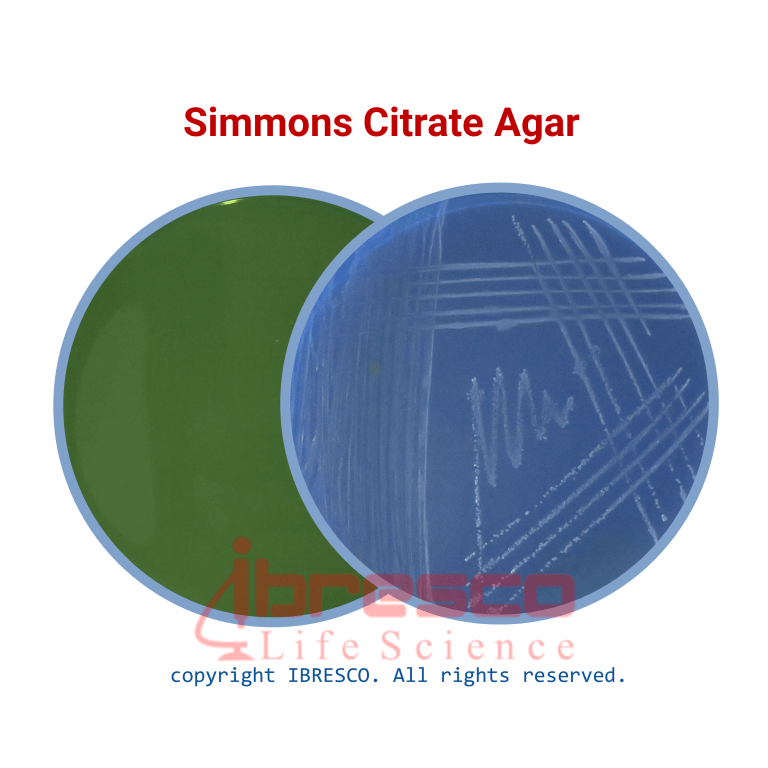

SIMMONS Citrate Agar | سیمونز سیترات آگار ایبرسکو
کاربرد: برای شناسایی باکتری های گرم منفی براساس مصرف سیترات. باکتری هایی که سیترات را استفاده می کنند، رنگ محیط را به آبی تغییر می دهند.
دسته: محیط کشت
ویژگی ها
- ضمانت اصالت کالا
- ارسال سریع کالا
- مشاوره کاهش هزینه ها
- خرید بهترین برندهای خارجی و داخلی با قیمت مناسب
- پشتیبانی 24 ساعته
- امکان سفارش در حجم و اندازه مورد نیاز بسیاری از محصولات
- 8161 351 935 98+
کاربرد: برای شناسایی باکتری های گرم منفی براساس مصرف سیترات. باکتری هایی که سیترات را استفاده می کنند، رنگ محیط را به آبی تغییر می دهند.
آماده سازی محیط
- قوطی محیط کشت سیمونز سیترات آگار را به خوبی تکان دهید. به میزان 22.3 گرم از پودر را وزن کنید و در 1 لیتر آب مقطر حل کنید. به خوبی مخلوط کنید. پیش از استفاده از آب مقطر، میزان pH آب را چک کنید تا بین 6.5 تا 7 باشد. اگر به این نکته توجه نشود، رنگ اولیه محیط می تواند متفاوت باشد.
- به خوبی هم بزنید و محیط را گرم کنید. اجازه دهید به مدت 1 دقیقه بجوشد تا پودر کاملا در آب حل شود.
- به مدت 15 دقیقه در دمای 121 درجه سانتی گراد اتوکلاو کنید.
- اجازه دهید محیط خنک شود. در لوله آزمایش و به شکل اسلنت بریزید. همچنین امکان استفاده از محیط در پلیت نیز وجود دارد.
شرایط نگهداری
پودر محیط داخل قوطی کاملا در بسته و در دمای زیر 30 درجه سانتیگراد و محیط آماده در دمای 8-2 درجه سانتیگراد نگهداری شود. بهترین زمان استفاده تا قبل از تاریخ انقضای درج شده بر روی برچسب محصول است.
کنترل کیفی
- ظاهر محیط دهیدراته: بژ-سبز روشن، پودر، یکنواخت و هموژن
- ظاهر محیط آماده: سبز تیره تا متوسط، شفاف تا کمی کدر، با میزان کمی رسوب و مواد نامحلول
- نتیجه کشت باکتری پس از گرماگذاری در دمای 2 ± 35 درجه سانتی گراد به مدت 48-24 ساعت
| Color change to blue | Recovery | ATCC | Organism |
|---|---|---|---|
|
–
|
None/poor
|
25922
|
Escherichia coli
|
|
Alkaline (blue)
|
Good
|
13047
|
Enterobacter cloacae
|
|
Alkaline (blue)
|
Good
|
8090
|
Citrobacter freundii
|
|
–
|
None/poor
|
12022
|
Shigella flexneri
|
| گرم بر لیتر | ترکیبات |
|---|---|
|
5
|
Sodium Chloride
|
|
2
|
Sodium Citrate
|
|
1
|
Di Potassium Hydrogen Phosphate
|
|
1
|
Ammonium Di Hydrogen Phosphate
|
|
0.2
|
Magnesium Sulphate.7H2O
|
|
0.08
|
Bromothymol Blue
|
|
13
|
Agar
|
|
0.2 ± 6.6
|
pH
|
نمره 0 از 5
0 دیدگاه
نمره 5 از 5
0
نمره 4 از 5
0
نمره 3 از 5
0
نمره 2 از 5
0
نمره 1 از 5
0
اولین نفری باشید که دیدگاهی را ارسال می کنید برای “SIMMONS Citrate Agar | سیمونز سیترات آگار ایبرسکو” لغو پاسخ
محصولات پیشنهادی
دیدگاهها
حذف فیلترهاهیچ دیدگاهی برای این محصول نوشته نشده است.